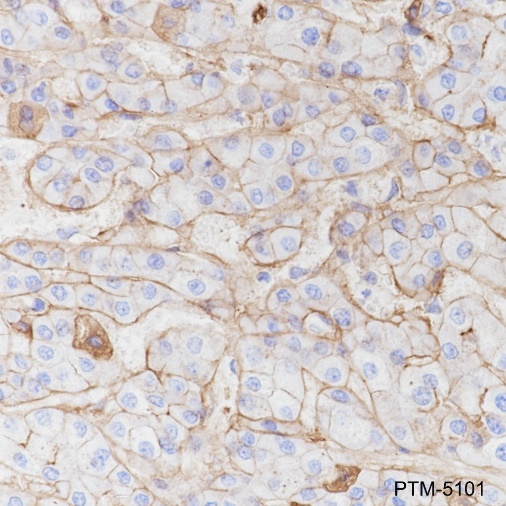

Background
Cell surface proteoglycan that bears both heparan sulfate and chondroitin sulfate and that links the cytoskeleton to the interstitial matrix. Regulates exosome biogenesis in concert with SDCBP and PDCD6IP.
Cellular location
Membrane

Clone Number: JRMR-147
Host: Rabbit Clonality: Recombinant Monoclonal
Applications: IHC-P
Reactivity: Human, Mouse
Synonyms: Syndecan-1, SYND1, CD138, SDC1, SDC
Shipping: Ambient temperature
Order online or send purchase order to info@ptmbio.com
| Isotype | IgG |
| Conjugate | Unconjugated |
| Synonyms | Syndecan-1, SYND1, CD138, SDC1, SDC |
| UniProt ID | |
| Immunogen | Synthetic peptide derived from human CD138 |
| MW (kDa) | / |
| Specificity |
| Applications | Dilution | Recommended Species |
|---|---|---|
| IHC-P | 1:200 - 1:1000 | Human, Mouse |
| Purity | Protein A purified |
| Constituents | PBS, Glycerol, BSA |
| Storage | Store at -20°C. Avoid freeze/thaw cycles. |
| Stability | Stable for 12 months from date of receipt/reconstitution. |
Background
Cell surface proteoglycan that bears both heparan sulfate and chondroitin sulfate and that links the cytoskeleton to the interstitial matrix. Regulates exosome biogenesis in concert with SDCBP and PDCD6IP.
Cellular location
Membrane
| IHC-P | |
|---|---|

|
Tissue: Human cervix |

|
Tissue: Human cervical carcinoma |
|
Tissue: Human liver cancer |

|
Tissue: Mouse kidney |
Research Use
For research use only, not for use in diagnostic procedures.